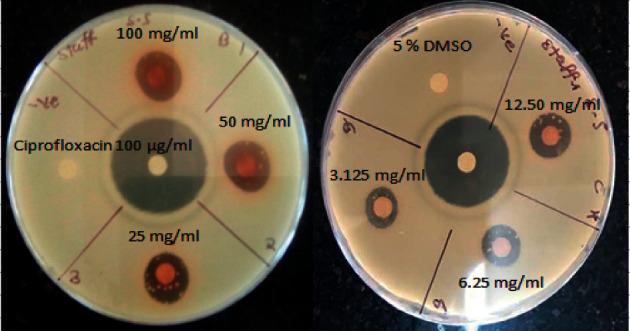
https://cdn.ncbi.nlm.nih.gov/pmc/blobs/d6b4/9410794/466119c4eede/ECAM2022-5436476.001.jpg

肯尼亚种植的(德利尔)乙酸乙酯叶提取物的气相色谱-质谱分析、抗菌及抗氧化潜力
GC-MS Analysis, Antibacterial and Antioxidant Potential of Ethyl Acetate Leaf Extract of (Delile) Grown in Kenya.
作者信息
Ochieng Nyalo Paul, Isanda Omwenga George, Piero Ngugi Mathew
机构信息
Department of Biochemistry, Microbiology and Biotechnology, Kenyatta University, P.O Box 43844-00100, Nairobi, Kenya.
Penda Health (K) Ltd, Medical Laboratory Department, P.O Box 22647-00100, Nairobi, Kenya.
出版信息
Evid Based Complement Alternat Med. 2022 Aug 18;2022:5436476. doi: 10.1155/2022/5436476. eCollection 2022.
Bacterial diseases are a leading cause of mortality and morbidity globally. During bacterial diseases, an elevation of host immune response occurs, which involves the production of free radicals in response to the bacterial infection. The overproduction of free radicals in excess of the antioxidants leads to oxidative stress. Conventional antibiotics are linked to side effects such as hypersensitivity reactions in addition to bacterial pathogens developing resistance against them. Artificial antioxidants are said to be carcinogenic. This study sought to confirm folklore use and validate the antibacterial and antioxidant potential of which has been widely used in the Mbeere community. The antibacterial potentials of the plant extract were investigated on ATCC 21332 ATCC 25922, ATCC 1408, and ATCC 25923. Ciprofloxacin (100 g/ml) drug was used as a standard reference, whereas 5% DMSO was used as a negative reference. The antibacterial tests included disc diffusion and minimum inhibitory and bactericidal concentrations. ethyl acetate extract showed broad-spectrum potential against tested bacterial microbes producing mean zones of inhibition (MZI) from 07.67 ± 0.33 to 17.67 ± 0.33 mm. The extract demonstrated a greater effect on Gram-positive than Gram-negative bacterial pathogens. Antibacterial properties of ciprofloxacin were significantly greater in comparison to plant extract in all the dilutions ( < 0.05), while 5% DMSO was inactive against all the tested bacteria. MBC values were greater than MIC values. Antioxidant properties of the extract were determined through scavenging effects of DPPH and hydroxyl radicals (OH) as well as ferric reducing antioxidant potential (FRAP) assay. demonstrated effects against all radicals formed. Additionally, the extract exhibited ferric reducing abilities. The extract also contained various phytocompounds with known antibacterial and antioxidant properties. This study recommends the therapeutic use of as an antibacterial as well as an antioxidant agent.
细菌性疾病是全球死亡率和发病率的主要原因。在细菌性疾病期间,宿主免疫反应会增强,这涉及到因细菌感染而产生自由基。自由基的过量产生超过了抗氧化剂的能力,从而导致氧化应激。传统抗生素除了会使细菌病原体产生耐药性外,还会引发如过敏反应等副作用。人工合成抗氧化剂据说具有致癌性。本研究旨在证实民间传说中的用途,并验证一种在姆贝雷社区广泛使用的植物的抗菌和抗氧化潜力。对该植物提取物对金黄色葡萄球菌ATCC 21332、大肠杆菌ATCC 25922、肺炎克雷伯菌ATCC 1408和铜绿假单胞菌ATCC 25923的抗菌潜力进行了研究。环丙沙星(100μg/ml)用作标准对照,而5%二甲基亚砜用作阴性对照。抗菌试验包括纸片扩散法以及最低抑菌浓度和最低杀菌浓度测定。该植物的乙酸乙酯提取物对受试细菌微生物显示出广谱潜力,产生的平均抑菌圈(MZI)为07.67±0.33至17.67±0.33毫米。该提取物对革兰氏阳性细菌病原体的作用比对革兰氏阴性细菌病原体的作用更大。在所有稀释度下,环丙沙星的抗菌性能均显著高于植物提取物(P<0.05),而5%二甲基亚砜对所有受试细菌均无活性。最低杀菌浓度值大于最低抑菌浓度值。通过二苯基苦味酰基自由基(DPPH)和羟基自由基(OH)的清除作用以及铁还原抗氧化能力(FRAP)测定来确定提取物的抗氧化性能。该提取物对所有形成的自由基均有作用。此外,该提取物还表现出铁还原能力。该提取物还含有多种具有已知抗菌和抗氧化特性的植物化合物。本研究建议将该植物作为抗菌和抗氧化剂进行治疗应用。